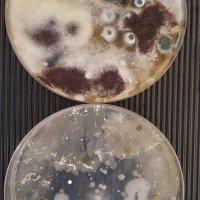
Aemidr (@aemidr) 's Twitter Profile Photo

Manuel Fankhauser
@manuelfankhaus
Entrepreneurial-minded biomedical scientist with a passion for disruptive innovations
ID: 3664276282
15-09-2015 13:19:31
239 Tweet
132 Takipçi
195 Takip Edilen

The Microbiota Vault featured in a news article in Science by Rodrigo Pérez Ortega about the importance of making microbiota collection and study more equitable. science.org/content/articl…

Excited and proud of this paper funded by the #SeeraveFoundation and co-lead by us on the link between the gut microbiome and clinical response to melanoma immunotherapy. Today in Nature Medicine nature.com/articles/s4159…

Fantastic work of our Segata Lab co-first author Andrew Thomas by other co-first authors Dr. Karla Lee and Laura Bolte, by coordinators Nicola Segata, Tim Spector MD (Prof), Rinse Weersma and all collaborators from CIBIO - UniTrento, IEO, King's College London and many others!

A truly multidisciplinary effort promoted by the Seerave Foundation that is funding a lot of impactful projects at the interface of human microbiome, cancer immunotherapy, and nutrition. Thanks everyone involved especially Dr. Karla Lee Andrew Thomas and Laura Bolte

A big thanks to the Seerave Foundation and Nicola Segata for their continued support and mentorship on this and many other projects. It was great learning experience working with Dr. Karla Lee, Laura Bolte, @AwfulDodger Tim Spector MD (Prof) Segata Lab and many others!


We are thrilled to see this collaborative work published in Nature Medicine - Highlighting the importance of the gut microbiome for response of cancer immunotherapy. Congrats to Nicola Segata Andrew Thomas Laura Bolte Dr. Karla Lee @AwfulDodger et al. nature.com/articles/s4159…

"Please join me in defending international liberal order" Timothy Garton Ash #SEF17 #LiveTheWild Swiss Economic Forum





Surprise discovery: #Tumor lymphangiogenesis can actually boost #immunotherapy Manuel Fankhauser Science Translational Medicine go.epfl.ch/aEf

Surprise discovery: #Tumor lymphangiogenesis can actually boost #immunotherapy Manuel Fankhauser Science Translational Medicine go.epfl.ch/aEf

Congrats everyone involved! #Lymphatics boost #cancer #immunotherapy. Science Translational Medicine ScienceLife EPFL bit.ly/2xAOsww




Attending to the #IMAGINEIF2017 Swiss Finals sessions #Lausanne. Amazing pitches!! Thanks IF Lausanne Innovation Forum for organizing #startup




